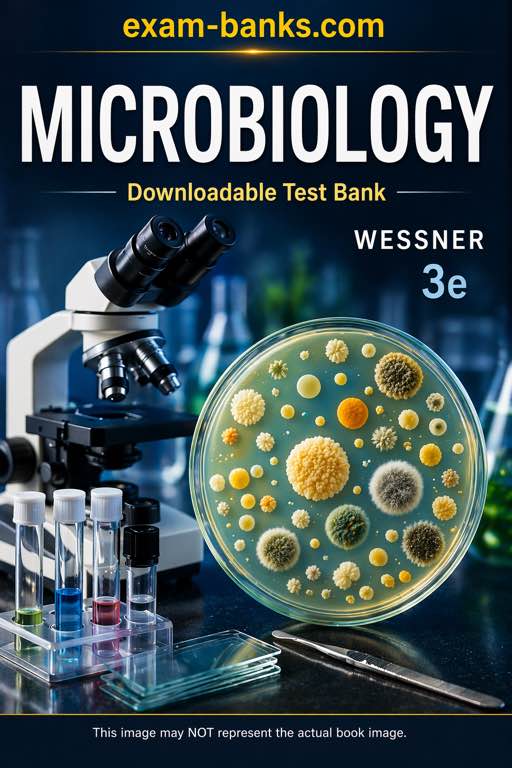

Description
Exam Support • Test Bank
Microbiology by Wessner, 3rd Edition
Built for Microbiology, BIOL 240, Biology 101, and MCB 100 courses
1800
Approx. Questions
24
Main Topics
✓
Word Files
Microbiology Test Questions
Microbiology is a fascinating topic but at the same time, many students struggle to pass it. Using a test bankis the best way to handle the pressure of college science. The reason is lack of practice, you read the book, attend classes, but when you sit for an exam you feel as if you didn’t study at all.
Often, the reason is that professors deliberately hide some information or specific details and reveal it only during exams. The purpose is to distinguish students who deeply understand the material from those who only know the basics.
Prepare for BIOL 240 with Wessner 3e
This material specifically matches Microbiology by Wessner, 3rd edition. This textbook is used in major courses like Biology 101 or MCB 100. This test bank helps you move past just reading definitions. This test collection provides access to a pool of text-specific practice test questions that keep you ready for any trick questions.
This material specifically matches Microbiology by Wessner, 3rd edition. This textbook is used in major courses like Biology 101 or MCB 100. This test bank helps you move past just reading definitions. This test collection provides access to a pool of text-specific practice test questions that keep you ready for any trick questions.
Key Features for Your Success
• Get around 1800 original high quality test questions.
• All content is written by Microbiology professors and scholars.
• There is a special word file for each chapter so you will never get confused with questions.
• Each question is accompanies by: correct answer, difficulty (easy, medium and hard), learning objective, and section reference (so that you can refer back to the textbook for further reading).
• Get around 1800 original high quality test questions.
• All content is written by Microbiology professors and scholars.
• There is a special word file for each chapter so you will never get confused with questions.
• Each question is accompanies by: correct answer, difficulty (easy, medium and hard), learning objective, and section reference (so that you can refer back to the textbook for further reading).
Using these practice questions is a sure way to secure a passing grade and keep a high GPA. This test bank ensures you are ready for the final. Buy now.
🔬 Topics Covered in The Test Bank
Part I — The Microbes
The Microbial World
Bacteria
Eukaryal Microorganisms
Archaea
Viruses
Metabolism
Part II — Microbial Genetics
Cultivating Microorganisms
DNA Replication and Gene Expression
Viral Replicating Strategies
Bacterial Genetic Analysis and Manipulation
Microbial Genomics
Regulation of Gene Expression
Part III — Microbial Physiology and Ecology
Biogeochemical Cycles
Microbial Ecosystems
Microbial Symbionts
Microbial Biotechnology
The Microbiology of Food and Water
Part IV — Microbes and Disease
Introduction to Infectious Diseases
Innate Host Defenses Against Microbial Invasion
Adaptive Immunity
Bacterial Pathogenesis
Viral Pathogenesis
Eukaryal Pathogenesis
Control of Infectious Diseases
🧪 Ready for the Final?
Use these chapter-based practice questions to strengthen your microbiology exam preparation.
Buy Now
We are not affiliated with textbook publishers.

Reviews
There are no reviews yet.